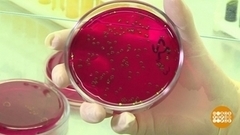
Больше бактерий, хороших и разных! Доброе утро. Фрагмент

Бактерии, хорошие и разные. Доброе утро. Фрагмент выпуска от 07.11.2023
В каждом из нас живут два-три килограмма бактерий. И они нам необходимы! Без них мы, например, бы не смогли есть овощи и фрукты. А еще у нас есть бактерия, которая помогает похудеть!
Внутри нас — настоящая химическая лаборатория из примерно трех-четырех тысяч разновидностей микроорганизмов. Часть из них нейтральные и полезные, часть условно-патогенные — то есть безобидные, пока их не становится слишком много. Чем разнообразнее у нас микробиом, тем крепче иммунитет. Чтобы поддержать разные виды бактерий, есть нужно как можно разнообразнее и в меру.
Комментируют врач-гастроэнтеролог, диетолог Елена Костырко и заместитель генерального директора биотехнического производства Наталья Гелеверя.
Вместе с этим смотрят
Больше бактерий, хороших и разных! Доброе утро. Фрагмент

О чем сигналит организм? Доброе утро. Суббота. Фрагмент

Кто, кто в холодильнике живет? Бактерии… Доброе утро. Фрагмент

Мобильные бактерии. Доброе утро. Фрагмент выпуска от 09.11.2017
